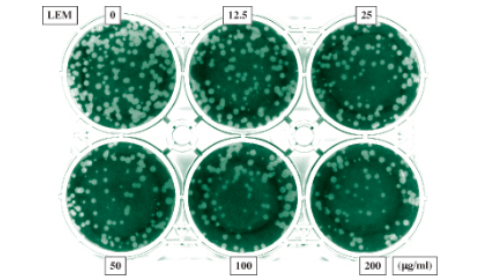

LEMエビデンス 学術レポート
LEMエビデンス
学術レポート
LEMの抗ウイルス作用
LEMはウイルスの増殖を抑制する
Agric.Biol.Chem.,54,1337(1990)
Anti-viral Activity of Water-solubilized Lignin Derivatives in vitro
反町、山崎、安村、他 : 獨協医大 (微)、東大 (農化)
VERO-317培養細胞を用いてin vitroで抗ウイルス活性を調べた。LEMより分画精製したEP3は、100μg/mlでヘルペスウイルスのタイプ1、タイプ2の各株及びWEEウイルス(西部ウマ脳炎ウイルス)の増殖(CPE)を完全に抑制した。また、ポリオ、はしか、おたふくかぜの各ウイルスに対しても抑制効果を示した。
Virus | CPE抑制効果 | ||||
単純ヘルペス | |||||
HSV-1 | |||||
Yasumura | +++ | ||||
UR-3 | +++ | ||||
HSV-2 | |||||
UW | +++ | ||||
MS | +++ | ||||
WEE | +++ | ||||
Porio | + | ||||
Mumps | + | ||||
Measles | + |
LEMは単純ヘルペスウイルス1型に特有なグリコプロテインの発現を減少させ、増殖を抑制する
Antiviral Research,20,293(1993)
Anitiviral effect of the extract of culture medium of Lentinus edodes mycelia on the replication of herpes simplex virus type 1
S.Sarkar, J.Koga, R.J.Whitley and S.Chatterjee
アラバマ大学小児科・微生物学科、日本ケミカルリサーチ(株)
サル腎臓細胞(BS-C-1細胞)を用いて感染性単純ヘルペスウイルス1型(HSV-1)放出抑制能について調べた。LEMから膜濾過についでカラムクロマトにより精製した画分JLS-S001を調製した。BS-C-1細胞にHSV-1を感染させた後にJLS-S001で処理し、プラークアッセイ法で感染能を測定した結果、20μg/mlで50%抑制し、300μg/mlで完全に阻害した。さらに、上記処理したBS-C-1細胞からタンパクを抽出し、ポリアクリルアミドゲル電気泳動後イムノブロッティングした結果、JLS-S001処理によってウイルスに特有なグリコプロテインB、C、D、E、I、の発現が抑制された。
濃度 (㎍/㎖) |
プラーク数 (UNITS/㎖) |
抑制率 (%) |
0 | 8.0×107 | 0 |
20 | 4.0×107 | 50 |
50 | 3.0×107 | 62.5 |
100 | 3.0×107 | 96.2 |
300 | 2.0×107 | 99.9 |
LEMはエイズウイルスなどのレトロウイルスの増殖を抑制する
第36回日本ウイルス学会
種々のヒトレトロウイルスによる細胞融合に対する抗HIV剤の影響
栃倉、中島、山本:山口大(医・寄生体)
Tリンパ球を破壊する後天性免疫不全症候群(エイズ)の原因ウイルス(HIV)やTリンパ球をガン化する成人T細胞白血病(ATL)の原因ウイルス(HTLVー1)はレトロウイルスとして知られているが、これらの病状に対し未だ有効な治療薬がなく、HIVでは変異株の存在が問題となっている。今回抗HIV-1剤について種々のHIV分離株、HTLVー1に対する抗ウイルス効果をcell-free infection, cell-to-cell infectionの系を用いて検討した。LEMを50%エタノールで沈澱した画分(E-P-LEM)はHIV-1、HIV-2を用いたcell-freeの系でHIV増殖抑制効果が株間に共通して認められ、cell-to-cellの系でも抗HIV効果が認められた。HTLV-1に対しても同様な抗ウイルス効果を示した。HIVはenvelopeの抗原性が多様に変化することが大きな障害となっているが、異なるHIV株間でも抗HIV活性が認められたことで、有用な抗HIV薬となり得ると考えられ、抗HTLV-1効果も期待できる。
Assay system | VIRUS | 抗ウイルス活性 | |
EP-LEM | AZT | ||
Cell free infection MT-4におけるウイルス抗原発現の抑制及びCPEの抑制効果 | HIV-1(HTLV-ⅢB) LAV ARV YU-6 HIV-2 |
〇 〇 〇 〇 〇 |
〇 〇 〇 〇 〇 |
Cell-to-cell infection 多核巨細胞形成の抑制 |
HIV-1(HTLV-ⅢB) LAV ARV YU-6 HIV-2 HTLV-1 |
〇 〇 〇 〇 〇 〇 |
〇 〇 〇 〇 〇 〇 |
LEMはエイズウイルスの発症を抑える
第5回日本エイズ医学会総会
HIV感染血友病患者に対するLEMの免疫学的効果
白幡、丸山、佐藤、木村、森 他:産業医大(児)、鹿児島大(3内)、鹿児島生協病院(児)、国療宮崎東(児)、国療宮崎(児)、久留米大(児)、浜の町病院(児)、東北大(3内)
血液凝固製剤で感染した血友病HIV感染患者に、LEMを1日6g〜9g、少なくとも1年以上投与した血友病A24例、B5例に対する免疫能改善効果、臨床症状について検討した。HIV病型はAIDS2例、ARC1例、AC26例であり、投与開始時のCD4実数は、250/μl以下が2例、251〜500/μlが13例、501〜750/μlが10例、751/μl以上が4例であった。本試験は最長25ヶ月迄実施し、試験期間中はAZTおよび他の免疫調節剤は一切投与されていない。投与前と比べて20%以上の増減を変化ありとみなした一定の点数法によりCD4実数の変動CD4/CD8の変化、PHA、ConA、PWMによるリンパ球芽球化試験について評価した結果、有効率は60%を越えた。HIV感染に対するこれらの成績は、経口投与では従来の物質は50%以下である点からみて、「LEM」の有用性が高く評価された。
1年後 | 2年後 | |
症例数 | 30例 (100%) | 12例 (100%) |
著効 | 7例 (23%) | 2例 (17%) |
有効 | 7例 (23%) | 2例 (17%) |
無効 | 3例 (10%) | 5例 (42%) |
悪化 | 13例 (43%) | 3例 (25%) |
第9回日本エイズ医学会総会
HIV感染血友病患者の免疫能に対するLEMの長期的効果
酒井、浦野、有吉、白幡:産業医大(児)
LEMを投与したHIV感染血友病患者7例のうち4年以上LEMを服用している血友病A患者5例について検討した。LEMは1日9gを3分割服用した。5例のうち怠薬の少なかった4症例はLEM単独服用であり、4年以上の観察にも拘わらずCD4の減少は認められず、副作用も認められなかったことから、HIV感染に対するLEMの長期的な効果が示唆された。

LEMはA型インフルエンザウイルスの感染と増殖を抑制する
A型インフルエンザウイルスの感染に及ぼす影響宿主細胞へのウイルス感染阻止作用
筑波大学大学院 人間総合科学研究科(基礎医学系感染生物学)
LEMが細胞へのインフルエンザウイルス感染抑制効果を有するか検討した。A型インフルエンザウイルスに所定濃度のLEM溶液を混合し、その後細胞へ添加してプラークアッセイにより感染価を測定した。結果、LEMは濃度依存的にプラーク数の減少が認められ、宿主細胞へのインフルエンザウイルス感染阻害作用を有することが示唆された。
A型インフルエンザウイルスの増殖に及ぼす影響ウイルスの複製過程抑制作用
筑波大学大学院 人間総合科学研究科(基礎医学系感染生物学)
LEMがインフルエンザウイルスの増殖抑制効果を有するか検討した。細胞にA型インフルエンザウイルスを感染させ、その後所定濃度のLEM溶液を添加し、プラークアッセイにおいてプラーク拡大を測定した。結果、プラークの大きさがLEMの濃度依存的に拡大抑制することが確認され、LEMによりインフルエンザウイルスの複製過程が抑制され、それにより増殖を抑制することが示唆された。
